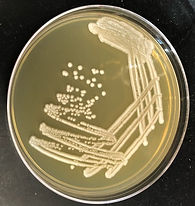
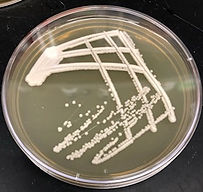

Summer 2018:
STEP 4: Identifying Yeast - Agar Plates
Here are the pictures of your samples after they have been allowed to grow on agar plates. Agar plates contain nutrients that allow the organisms to quickly grow into colonies that are large enough to see with the naked eye. Yeasts typically grow into round, creamy white colonies that are somewhat raised.
Click the link to learn more about the science behind this step of the Yeasty Beasties process.


Fresh
And
Clean
#500
No growth of yeasts :(
Please submit more!
#510
No growth of yeasts :(
Yellow growth is bacteria. The large, fuzzy growth is filamentous fungi.
#511
No growth of yeasts :(
A filamentous fungi has taken over the plate. Please submit more!
#512
Looks like yeasts!
Moving to STEP 5...
#513
No growth of yeasts :(
The slimy, shiny colonies are bacteria and the fuzzy white and blue colonies are fungi.
#514
Growth of filamentous fungi :(
Please submit more!
#515
Round and creamy colonies - Could be yeast! Moving to STEP 5...
#516
Dull, cream colored colonies. Good chance of yeast growth!
Moving to STEP 5...
#520
Colonies are small, but look like yeasts!
Moving to STEP 5...
#521
No growth observed :(
Please submit more!
#522
Round and dense, cream colored colonies. Might be yeasts! Moving to STEP 5...
#523
Very dense, creamy colonies.
Moving to STEP 5...
#526
Growth of a filamentous fungi :(
Please submit more!
#527
No growth observed :(
Please submit more!
#528
Looks like yeasts! Moving to STEP 5...
#529
Dense off-white colonies. Most likely yeasts!
Move to STEP 5...
#530
Colonies are dense with a creamy texture. Looks like yeast! Moving to STEP 5...
#531
Plate growth from this sample looks like yeasts!
Moving to STEP 5...
#532
Dense, creamy, off-white colonies -
Looks like yeasts!
Moving to STEP 5...
#17
No growth observed :(
Please submit more!
#534
Colonies are dense, round, and an off-white color. Looks like yeasts! Moving to STEP 5...
#536
Not a lot of growth, but these small colonies look like yeasts. Moving to STEP 5...
#537
Creamy-white colonies with mucoid texture. Possibly bacteria, but proceeding to STEP 5...
#538
Smaller colonies are likely bacteria. Large white colonies look like yeasts! Moving both species to STEP 5...
#539
Colonies are smaller, but look like yeasts -
Moving to STEP 5...
#540
No growth observed :(
Please submit more!
#541
Dense, creamy off-white colonies -
Moving to STEP 5...
#542
Looks like yeasts! Moving to STEP 5...
#543
Colonies are small, but meet the yeasts description!
Moving to STEP 5...
#544
Very dense, larger white colonies.
Moving to STEP 5...
#545
Sample growth looks like yeasts!
Moving to STEP 5...
#546
Colonies are dense and have creamy texture.
Most likely yeast growth!
Moving to STEP 5...
#547
No growth observed :(
Please submit more...
#548
Dense, off-white colonies, Looks like yeasts!
#549
Yep! Looks like yeasts...
Moving to STEP 5...
#550
Growth of the wrong type of fungi :(
Please submit more...
#551
Smaller, tan colored colonies.
Still could be yeasts!
Moving to STEP 5...
#552
Beautiful round, chalk textured colonies -
Looks like yeast!
Moving to STEP 5...
#553
Plate growth looks like yeasts!
Moving to STEP 5...
#554
Round creamy colonies -
Probably yeasts!
Moving to STEP 5...
#555
Oops! No growth observed :(
Please submit more...
#556
Colonies have yeast characteristics!
Moving to STEP 5...
#557
Dense, chalk-textured colonies.
Moving to STEP 5...
#558
Sample growth looks like yeasts!
Moving to STEP 5...